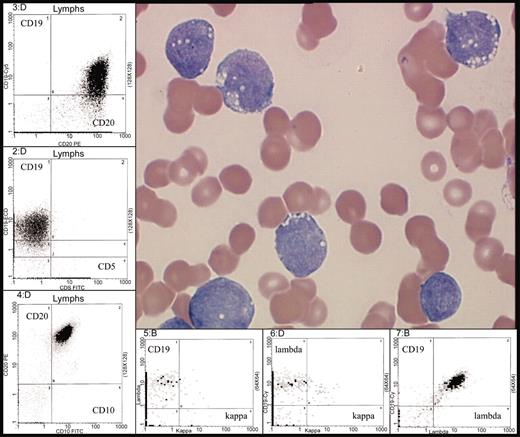
Figure 2. Typical morphology of Burkitt leukemia. Characteristic immunophenotype is illustrated by flow cytometric analysis: CD10+, CD19+, CD20+ (bright), surface immunoglobulin light chain λ restricted (bright) and CD5–. Peripheral blood involvement by BL (H&E stain) was photographed using the Olympus model BX50 microscope (Olympus UPlanF1 100X/1.30 oil). Photography was performed with the digital camera MTI model 3CCD, PAXit version 2.0 software, and Adobe Photoshop 7.0 imaging processing. For the flow cytometry inserts, data was acquired using a Coulter FC500 instrument (Beckman-Coulter, Fullerton, CA) with XCP version 1.2 analysis software (Beckman-Coulter).

Abstract
The World Health Organization Classification of Lymphoid Neoplasms identifies Burkitt lymphoma/leukemia as a highly aggressive mature B-cell neoplasm consisting of endemic, sporadic, and immunodeficiency-associated variants. These subtypes share many morphologic and immunophenotypic features, but differences exist in their clinical and geographic presentations. All of these subtypes possess chromosomal rearrangements of the c-myc oncogene, the genetic hallmark of Burkitt lymphoma that contributes to lymphomagenesis through alterations in cell cycle regulation, cellular differentiation, apoptosis, cellular adhesion, and metabolism. Brief-duration, high-intensity chemotherapy regimens containing aggressive central nervous system prophylaxis have had remarkable success in the treatment of this disease, with complete remission rates of 75% to 90% and overall survivals reaching 50% to 70% in adults. Although Burkitt lymphoma cells are extremely chemosensitive, biologically targeted therapies should be developed because current treatment options are suboptimal for patients with poor prognostic features or in the setting of relapsed disease.
Introduction
First described by Dennis Burkitt in 1958,1 Burkitt lymphoma (BL) is a highly aggressive non-Hodgkin lymphoma (NHL) often presenting in extranodal sites or as an acute leukemia. Originally thought to represent 2 different lymphoproliferative disorders, BL was historically classified as a small noncleaved cell lymphoma2,3 in patients with a solid tumor or nodal mass and as L3 acute lymphoblastic leukemia (FAB [French-American-British] L3 ALL)4 in patients with greater than 25% bone marrow involvement. However, on the basis of shared molecular and genetic features, the World Health Organization (WHO) Classification of Lymphoid Diseases5 recognizes the lymphoma and leukemic phases of BL as a single entity; a mature B-cell neoplasm, subtype Burkitt lymphoma/Burkitt cell leukemia. The hallmark of this disease is the overexpression of c-Myc, most commonly resulting from t(8;14), although variant translocations have been described.6
Clinical presentation of BL
Three different clinical variants of BL have been described: endemic, sporadic, and immunodeficiency BL. Although there is considerable overlap, unique clinical and genetic features have been described among these variants. The endemic form is most commonly observed in equatorial Africa, in children aged 4 to 7 years, with frequent involvement of the jaw and kidneys, although ileal, cecal, ovarian, and breast involvement have also been reported. The particularly high incidence of BL in equatorial Africa (50-fold higher than in the United States) and the geographic distribution of this tumor, corresponding to the distribution of endemic malaria, have led to its designation as endemic BL. In contrast, in other geographic areas, most patients present with abdominal tumors with no specific geographic or climatic distribution. This clinical variant, designated sporadic BL, accounts for 1% to 2% of all adult lymphomas in Western Europe and the United States.7 The immunodeficiency subtype is frequently observed in the setting of human immunodeficiency virus (HIV) infection and, unlike other HIV-related lymphomas, is frequently noted in patients with CD4 counts exceeding 200 cells/μL.8 Adult patients with sporadic or immunodeficiency-associated BL typically present with extranodal disease, with the abdomen being the most frequent site of involvement. Symptoms can include abdominal pain, nausea, vomiting, bowel obstruction, gastrointestinal bleeding, or syndromes mimicking acute appendicitis or intussusception. Intraabdominal presentations usually affect the bowel or intraabdominal lymph nodes, although kidney, pancreas, liver, spleen, breast, or ovarian involvement can occur. At diagnosis, patients usually have bulky disease and elevated lactate dehydrogenase and uric acid levels. Bone marrow and central nervous system (CNS) involvement is reported in 30% to 38% and 13% to 17% of adults, respectively.9-11
Because of the frequency of extranodal disease, several different staging systems have been used for BL. Adult trials frequently reference the Ann Arbor system, although some researchers find this system inadequate because of its inability to fully describe the extent of extranodal involvement. Therefore, some trials report stage according to the St Jude or Murphy staging schema (Table 1). It is important to note that this staging system recognizes Burkitt leukemia as a separate entity, unlike the current WHO classification.5 Also, this staging system was developed when surgery was often used for both diagnostic and therapeutic purposes, with the goal of surgery often being complete resection of intra-abdominal disease. Current therapy of BL does not routinely incorporate debulking surgery because of the existence of highly effective chemotherapy and an increased rate of local complications and toxic death with early surgery.12
St Jude/Murphy Staging System for BL
Stage . | Description . |
|---|---|
| I | A single tumor (extranodal) or a single anatomic area (nodal) with the exclusion of the mediastinum or abdomen. |
| II | A single extranodal tumor with regional node involvement. |
| Two single extranodal tumors on the same side of the diaphragm with or without regional node involvement. | |
| Primary gastrointestinal tumor with or without involvement of associated mesenteric nodes only. | |
| Two or more nodal areas on the same side of the diaphragm. | |
| IIR | Completely resected intra-abdominal disease. |
| III | Two single extranodal tumors on opposite sides of the diaphragm. |
| All primary intrathoracic tumors (mediastinal, pleural, thymic). | |
| All paraspinal or epidural tumors, regardless of other tumor sites. | |
| All extensive primary intra-abdominal disease. | |
| Two or more nodal areas on opposite sides of the diaphragm. | |
| IIIA | Localized but nonresectable intra-abdominal disease. |
| IIIB | Widespread multiorgan abdominal disease. |
| IV | Any of the above with initial CNS and/or bone marrow involvement (less than 25% involvement; greater than 25% involvement is defined as L3 ALL). |
Stage . | Description . |
|---|---|
| I | A single tumor (extranodal) or a single anatomic area (nodal) with the exclusion of the mediastinum or abdomen. |
| II | A single extranodal tumor with regional node involvement. |
| Two single extranodal tumors on the same side of the diaphragm with or without regional node involvement. | |
| Primary gastrointestinal tumor with or without involvement of associated mesenteric nodes only. | |
| Two or more nodal areas on the same side of the diaphragm. | |
| IIR | Completely resected intra-abdominal disease. |
| III | Two single extranodal tumors on opposite sides of the diaphragm. |
| All primary intrathoracic tumors (mediastinal, pleural, thymic). | |
| All paraspinal or epidural tumors, regardless of other tumor sites. | |
| All extensive primary intra-abdominal disease. | |
| Two or more nodal areas on opposite sides of the diaphragm. | |
| IIIA | Localized but nonresectable intra-abdominal disease. |
| IIIB | Widespread multiorgan abdominal disease. |
| IV | Any of the above with initial CNS and/or bone marrow involvement (less than 25% involvement; greater than 25% involvement is defined as L3 ALL). |
Morphology and immunophenotype of BL
In addition to the different clinical variants of BL, 2 morphologic variants have been identified: classic BL and atypical or Burkitt-like lymphoma (BLL).5,13 Medium-sized cells with abundant, basophilic cytoplasm, often containing lipid vacuoles; round nuclei with clumped chromatin and multiple nucleoli; and a diffuse, monotonous pattern of infiltration are characteristic of classic BL.7,13 A “starry sky” appearance has been described in this type of NHL because of its abundant proliferative rate, frequent apoptoses, and numerous macrophages containing ingested apoptotic tumor cells (Figure 1A-B). The Burkitt-like variant, a provisional entity in the REAL (Revised European-American Lymphoma) classification13 and a subcategory of BL in the WHO classification,5 has greater pleomorphism in nuclear size and shape, with fewer nucleoli than classic BL. In many cases, BLL has features intermediate between diffuse large B-cell lymphoma (DLBCL) and BL, making pathologic diagnosis difficult. In fact, the degree of consensus among pathologists making the diagnosis of BLL was only 53% using the REAL classification.14 This lack of reproducibility may be related to the histologic, clinical, and genetic heterogeneity of BLL, with a variety of reviews reporting differing characteristics of BLL, including translocation of t(14:18), lack of c-myc rearrangements, and more frequent nodal presentations.15,16 Currently, the WHO Classification of Lymphoid Diseases requires that BLL demonstrates a high growth fraction, with Ki67 staining exceeding 99%, with cytogenetic evidence of a c-myc rearrangement, when cytogenetic analysis is available.5
Typical morphology of bone marrow or lymph node involvement in BL. (A) Typical morphology of bone marrow with involvement by BL. Characteristic immunophenotype illustrated by immunohistochemistry: CD20+, CD10+, Ki67+ (100%), TdT– (terminal deoxynucleotidyl transferase), and CD34–. Classic translocation involving c-myc and immunoglobulin heavy chain genes is illustrated by fluorescence in situ hybridization (FISH) analysis with probes for 14q32 (immunoglobulin heavy chain [IgH]), green; 8q24 (MYC), red; and chromosome 8 centromere probe, aqua. Fusion product t(8;14)(q24:q32) in yellow (indicated by arrows). (B) Typical morphology of lymph node with involvement by BL. Characteristic immunophenotype illustrated by immunohistochemistry: CD20+, CD10+, Ki67+ (100%), TdT–, and CD34–. Classic translocation involving c-myc and immunoglobulin heavy chain genes is illustrated by FISH analysis with probes for 14q32 (IgH), green; 8q24 (MYC), red; and chromosome 8 centromere probe, aqua. Fusion product t(8;14)(q24;q32) in yellow (indicated by arrows). The large images of bone marrow and lymph node involvement in panels A and B were obtained using an Olympus BX50 microscope (Olympus, Tokyo, Japan) equipped with an Olympus UPlanF1 40 ×/0.75 objective lens (H&E images of bone marrow and lymph node), or an Olympus UPlanF1 20 ×/0.50 objective lens (CD20, CD10, Ki67, TdT, and CD34 immunohistochemistry stains). Photography was performed with an MTI 3CCD digital camera (DAGE-MTI, Michigan City, IN), PAXit 2.0 acquisition software (MIS, Franklin Park, IL), and Adobe Photoshop 7.0 imaging software (Adobe, San Jose, CA). The immunohistochemical stains were obtained using DAKO autostainer universal staining system (DAKOCytomation, Carpinteria, CA) and the following antibodies: CD10 clone 56C6 (Novocastra, Newcastle upon Tyne, United Kingdom), CD20 clone L26 (DAKOCytomation, Glostrup, Denmark), CD34 clone QBEND10 (Immunotech, Marseilles, France), Ki67 clone MIB-1 (DAKOCytomation), and TdT clone A3524 (DAKOCytomation). The FISH insert images were acquired using the Vysis IgH/MYC/CEP-8 Dual Fusion DNA probe (Vysis/Abbott, Downers Grove, IL), a Zeiss Axioskop microscope equipped with a Zeiss PlanApo 100 × oil immersion objective lens and dual band pass filter (Carl Zeiss, Thornwood, NY), and Applied Spectral Imaging (Vista, CA) digital camera and software version 3.0.
Typical morphology of bone marrow or lymph node involvement in BL. (A) Typical morphology of bone marrow with involvement by BL. Characteristic immunophenotype illustrated by immunohistochemistry: CD20+, CD10+, Ki67+ (100%), TdT– (terminal deoxynucleotidyl transferase), and CD34–. Classic translocation involving c-myc and immunoglobulin heavy chain genes is illustrated by fluorescence in situ hybridization (FISH) analysis with probes for 14q32 (immunoglobulin heavy chain [IgH]), green; 8q24 (MYC), red; and chromosome 8 centromere probe, aqua. Fusion product t(8;14)(q24:q32) in yellow (indicated by arrows). (B) Typical morphology of lymph node with involvement by BL. Characteristic immunophenotype illustrated by immunohistochemistry: CD20+, CD10+, Ki67+ (100%), TdT–, and CD34–. Classic translocation involving c-myc and immunoglobulin heavy chain genes is illustrated by FISH analysis with probes for 14q32 (IgH), green; 8q24 (MYC), red; and chromosome 8 centromere probe, aqua. Fusion product t(8;14)(q24;q32) in yellow (indicated by arrows). The large images of bone marrow and lymph node involvement in panels A and B were obtained using an Olympus BX50 microscope (Olympus, Tokyo, Japan) equipped with an Olympus UPlanF1 40 ×/0.75 objective lens (H&E images of bone marrow and lymph node), or an Olympus UPlanF1 20 ×/0.50 objective lens (CD20, CD10, Ki67, TdT, and CD34 immunohistochemistry stains). Photography was performed with an MTI 3CCD digital camera (DAGE-MTI, Michigan City, IN), PAXit 2.0 acquisition software (MIS, Franklin Park, IL), and Adobe Photoshop 7.0 imaging software (Adobe, San Jose, CA). The immunohistochemical stains were obtained using DAKO autostainer universal staining system (DAKOCytomation, Carpinteria, CA) and the following antibodies: CD10 clone 56C6 (Novocastra, Newcastle upon Tyne, United Kingdom), CD20 clone L26 (DAKOCytomation, Glostrup, Denmark), CD34 clone QBEND10 (Immunotech, Marseilles, France), Ki67 clone MIB-1 (DAKOCytomation), and TdT clone A3524 (DAKOCytomation). The FISH insert images were acquired using the Vysis IgH/MYC/CEP-8 Dual Fusion DNA probe (Vysis/Abbott, Downers Grove, IL), a Zeiss Axioskop microscope equipped with a Zeiss PlanApo 100 × oil immersion objective lens and dual band pass filter (Carl Zeiss, Thornwood, NY), and Applied Spectral Imaging (Vista, CA) digital camera and software version 3.0.
BL cells express surface IgM, Bcl-6, CD19, CD20, CD22, CD10, and CD79a, and are negative for CD5, CD23, and TdT (Figures 1, 2). In contrast, precursor B-cell ALL is usually TdT-positive and does not express surface immunoglobulin. The expression of Bcl-6 (B-cell lymphoma 6) and CD10 suggest a germinal center origin for BL. Sequence analysis of the Ig variable heavy chain and light chain genes in BL confirms that the endemic, sporadic, and immunodeficiency-associated variants of BL have all arisen from a germinal center B cell, with evidence of somatic hypermutation.17-20
Typical morphology of Burkitt leukemia. Characteristic immunophenotype is illustrated by flow cytometric analysis: CD10+, CD19+, CD20+ (bright), surface immunoglobulin light chain λ restricted (bright) and CD5–. Peripheral blood involvement by BL (H&E stain) was photographed using the Olympus model BX50 microscope (Olympus UPlanF1 100X/1.30 oil). Photography was performed with the digital camera MTI model 3CCD, PAXit version 2.0 software, and Adobe Photoshop 7.0 imaging processing. For the flow cytometry inserts, data was acquired using a Coulter FC500 instrument (Beckman-Coulter, Fullerton, CA) with XCP version 1.2 analysis software (Beckman-Coulter).
Typical morphology of Burkitt leukemia. Characteristic immunophenotype is illustrated by flow cytometric analysis: CD10+, CD19+, CD20+ (bright), surface immunoglobulin light chain λ restricted (bright) and CD5–. Peripheral blood involvement by BL (H&E stain) was photographed using the Olympus model BX50 microscope (Olympus UPlanF1 100X/1.30 oil). Photography was performed with the digital camera MTI model 3CCD, PAXit version 2.0 software, and Adobe Photoshop 7.0 imaging processing. For the flow cytometry inserts, data was acquired using a Coulter FC500 instrument (Beckman-Coulter, Fullerton, CA) with XCP version 1.2 analysis software (Beckman-Coulter).
Genetic features of BL
Eighty percent of BL cases harbor t(8;14), resulting in the juxtaposition of the c-myc gene on chromosome 8 with IgH enhancer elements on chromosome 14 (Figure 3) which drive c-Myc mRNA and protein production.21 In the remaining 20% of BL cases, translocations occurring between chromosomes 2 and 8, t(2;8)(p12;q24), or chromosomes 8 and 22, t(8;22)(q24;q11), place the c-myc gene adjacent to either κ or λ light chain loci and enhancer elements (Figure 3), respectively.21-23 As heavy chain and light chain loci are specifically active in mature B cells, it is not difficult to understand how c-myc transcription is favored in BL harboring t(8;14), t(2;8), or t(8;22).
Positions of c-myc, IgH, Igκ, or Igλ breakpoints in t(8;14), t(2;8), or t(8;22) Burkitt lymphoma. The breakpoints for t(8;14) in endemic BL (eBL), sporadic BL (sBL), and immunodeficiency BL (HIV BL) are depicted. Juxtaposition of the Eμ enhancer on the IgH gene of chromosome 14, Ei and E3′ enhancers in the κ locus of chromosome 2, and HuEλ enhancer in the λ locus of chromosome 22 with the c-myc gene on chromosome 8 drive c-Myc overexpression in BL with t(8;14), t(2;8), and t(8;22), respectively.
Positions of c-myc, IgH, Igκ, or Igλ breakpoints in t(8;14), t(2;8), or t(8;22) Burkitt lymphoma. The breakpoints for t(8;14) in endemic BL (eBL), sporadic BL (sBL), and immunodeficiency BL (HIV BL) are depicted. Juxtaposition of the Eμ enhancer on the IgH gene of chromosome 14, Ei and E3′ enhancers in the κ locus of chromosome 2, and HuEλ enhancer in the λ locus of chromosome 22 with the c-myc gene on chromosome 8 drive c-Myc overexpression in BL with t(8;14), t(2;8), and t(8;22), respectively.
Different breakpoints have been identified on chromosomes 8 and 14, depending on the clinical variant of BL (Figure 3; reviewed in Hecht and Aster21 and Boxer and Dang24 ). Although not a strict association, in endemic BL, the breakpoint on chromosome 8 generally occurs more than 100 kilobase (kb) upstream from the first coding region of the c-myc gene, with chromosome 14 breakpoints in the joining segments of the IgH gene. This t(8;14) translocation in endemic BL places the c-myc promoter in exon 1 under the control of the IgH Eμ enhancer element.21,22,25,26 In contrast, in sporadic and HIV-associated BL, the breakpoints occur between exons 1 and 2 of the c-myc gene and within the Sμ switch region of the IgH gene.21,22,25-27 In sporadic BL, the Eμ IgH enhancer is eliminated during the translocation, indicating that other IgH elements such as the Eα enhancer may be responsible for driving c-myc transcription.21,28
Pathogenesis of BL
C-Myc, a helix-loop-helix leucine zipper transcription (bHLH-LZIP) factor, influences the transcription of a variety of proteins involved in cell cycle regulation, apoptosis, cell growth, cell adhesion, and differentiation (Figure 4; reviewed in Hecht and Aster,21 Sanchez-Beato et al,29 and Dang et al30 ), making it difficult to attribute any single alteration to lymphomagenesis. Oligonucleotide array analysis has identified 27 genes that are consistently induced with c-Myc overexpression, including cyclin D2, genes for the nucleolar proteins nucleolin and fibrillarin, the apoptosis gene TRAP1 (a tumor necrosis factor receptor), the major histocompatibility gene HLA-DRB1, and the mitochondrial chaperone heat shock 60-kDa protein 1 (HSPD1).31 In addition, 9 genes, including genes for the cyclin-dependent kinase inhibitor p21CIP1, fibronectin, collagen, and platelet-derived growth factor receptor-α (PDGFRα), are consistently repressed with c-Myc overexpression.31 Other targets of c-Myc identified in knock-out or overexpression cellular or animal models include cyclin D1, cyclin-dependent kinase 2 (CDK2), cyclin-dependent kinase 4 (CDK4), p27, lactate dehydrogenase A (LDH A), p19ARF, p53, Bax, Fas, and Fas ligand.24,32-34
Direct and indirect consequences of c-Myc overexpression in Burkitt lymphoma. These consequences are reviewed in Hecht and Aster21 and Boxer and Dang.24 FAS indicates fatty acid synthetase; FASL, FAS ligand; Bax, Bcl-2–associated X protein; LDHA, lactate dehydrogenase A; LFA-1, lymphocyte function-associated antigen-1.
Direct and indirect consequences of c-Myc overexpression in Burkitt lymphoma. These consequences are reviewed in Hecht and Aster21 and Boxer and Dang.24 FAS indicates fatty acid synthetase; FASL, FAS ligand; Bax, Bcl-2–associated X protein; LDHA, lactate dehydrogenase A; LFA-1, lymphocyte function-associated antigen-1.
In addition to the c-myc translocations found in virtually all variants of BL, a number of other mutations affecting c-myc or other genes may be responsible for the evolution and progression of BL. Deletion or mutation or several negative regulatory elements within the c-myc gene may further enhance protein expression.35-37 C-Myc overexpression may also be related mutations in the threonine 58 residue of c-Myc.38-42 With this mutation, proteasome-mediated degradation of c-Myc is substantially impaired, allowing further accumulation of this oncoprotein.38,39 Mutations in p53,43-45 methylation of death-associated protein kinase (DAP-kinase),46 and Epstein-Barr virus (EBV)–induced FLICE (FADD [Fas-associated death domain protein]–like interleukin-1β-converting enzyme) inhibitory protein (FLIP) expression47 may all contribute to impaired apoptosis in BL. Likewise, changes in other cellular proteins, ie, down-regulation of p16INK4a or p15INK4b via gene hypermethylation,48 may promote cell cycle progression, providing additional hits to the cell cycle regulatory machinery in BL.
Treatment of BL
Historically, treatment of BL mimicked the high-intensity, prolonged regimens used for the treatment of ALL with induction, consolidation, and maintenance phases. Such therapy is generally ineffective for most patients with BL and results in low frequency of cure. The high-growth fraction of BL (doubling time of approximately 25 hours) favors re-entry of remaining viable malignant cells into the cell cycle and rapid growth between chemotherapy cycles with subsequent development of resistance. Short-duration, intensive regimens that minimize treatment delays and maintain serum drug concentrations over at least 48 to 72 hours have the greatest efficacy in BL.
Short-duration combination chemotherapy, first used in children with BL, consisting of intensive therapy with several known active agents in BL, including cyclophosphamide, vincristine, methotrexate, doxorubicin, and cytarabine, has improved upon the outcomes observed with ALL-like regimens, with 2-year disease-free survivals (DFS) reaching 75% to 89% in pediatric patients with advanced-stage BL.49-54 Several therapeutic strategies, including fractionated cyclophosphamide, alternation of non–cross-resistant cytotoxic agents between treatment cycles, a shortened duration of therapy, minimal treatment delays, and aggressive CNS prophylaxis, may be responsible for this success. With frequent involvement of the CNS and the bone marrow, adults were once thought to have a less favorable outcome than pediatric patients with BL; however, several studies suggest that treatment with intensive chemotherapy and adequate CNS prophylaxis can be curative even in the setting of advanced-stage disease or immunodeficiency.11,54-57 With high-intensity, brief-duration regimens, 65% to 100% of adults achieve a complete response (CR), with 47% to 86% of patients maintaining these remissions at least 1 year following therapy (Table 2).10,54,56,58,61-65,67 Several pediatric regimens, modified for use in adults, have been quite successful in the treatment of adult BL, including the French LMB 81, 84, 86, and 89 regimens; the German Berlin-Frankfurt-Munster (BFM) protocols; and CODOX-M/IVAC.11,53-55,62 Additional protocols, including the Stanford regimen, Hyper-CVAD, and Cancer and Leukemia Group B (CALGB) 9251,56,58,66,68 have been evaluated primarily in adults but incorporate many of the chemotherapeutic principles found to be effective in the treatment of pediatric BL. Comparison of these treatment regimens is difficult in adult BL because of (1) differences in patient populations among the trials, particularly in regard to patient age and stage; (2) differences in pathology (Burkitt leukemia or BLL is excluded in some trials); and (3) differences in staging, with several trials using the St Jude system, whereas others use the Ann Arbor system.
Results of treatment of adult BL
Reference . | Protocol . | No. of patients treated . | Median age, y (range) . | CR, % . | DFS, % . | EFS, % . | OS, % . |
|---|---|---|---|---|---|---|---|
| Bernstein et al58 | Stanford | 18 | 25 (15-75) | 78 | 71.3 at 1 y* | N/A | 66.8 at 2 y |
| Lopez et al59 | MD Anderson 81-01 and 84-30 | 44 | 32 (17-72) | 80 | 60 at 5 y* | N/A | 52 at 5 y |
| McMaster et al10 | Vanderbilt | 20 | 44.5 (21-69) | 85 | 60 at 5 y | N/A | N/A |
| Longo et al60 | ProMACE-MOPP | 17 | 36 (19-90) | 64.7 | 61 at 15 y | N/A | 35 at 15 y |
| ProMACE-Cytabom | 8 | 100 | 86 at 15 y | N/A | 88 at 15 y | ||
| Divine et al61 | ACVBP | 52 | 34 | 85 | N/A | 47 at 5 y | 53 at 5 y |
| Soussain et al11 | LMB 81, 84, 86, and 89 | 65 | 26 (17-65) | 89 | N/A | 71 at 3 y | 74 at 3 y |
| Divine et al62 | LMB 81, 84, 86, and 89 | 51 | 33 | 83 | N/A | 61 at 2 y | 66 at 2 y |
| Hoelzer et al55 | BNHL83 | 24 | 33 (15-38) | 63 | 50 at 8 y | N/A | 49 at 8 y |
| BNHL86 | 35 | 36 (18-65) | 74 | 71 at 4 y | 51 at 4 y | ||
| Todeschini et al63 | Modified POG 8617 | 8 | 35 (19-64) | 100 | N/A | 75 at 28 mo | N/A |
| Adde et al64 | CODOX-M/IVAC | 26 | 25 (18-59) | 92.3 | N/A | 84 at 1 y | N/A |
| LaCasce et al65 | CODOX-M/IVAC | 14 | 47 | 86 | 72 at 21 mo | N/A | N/A |
| Mead et al9 | CODOX-M/IVAC | 52 | 35 (15-60) | 75 | N/A | 64.6 at 2 y | 72.8 at 2 y |
| Thomas et al56 | Hyper-CVAD | 26 | 58 (17-79) | 81 | 61 at 3 y* | N/A | 49 at 3 y |
| Cabanillas et al66 | R-Hyper-CVAD | 20 | 52 (27-77) | 89 | 86 at 1 y | N/A | N/A |
| Lee et al67 | CALGB 9251 | 54 | 44 (18-71) | 80 | 50 at 4 y | N/A | 52 at 4 y |
Reference . | Protocol . | No. of patients treated . | Median age, y (range) . | CR, % . | DFS, % . | EFS, % . | OS, % . |
|---|---|---|---|---|---|---|---|
| Bernstein et al58 | Stanford | 18 | 25 (15-75) | 78 | 71.3 at 1 y* | N/A | 66.8 at 2 y |
| Lopez et al59 | MD Anderson 81-01 and 84-30 | 44 | 32 (17-72) | 80 | 60 at 5 y* | N/A | 52 at 5 y |
| McMaster et al10 | Vanderbilt | 20 | 44.5 (21-69) | 85 | 60 at 5 y | N/A | N/A |
| Longo et al60 | ProMACE-MOPP | 17 | 36 (19-90) | 64.7 | 61 at 15 y | N/A | 35 at 15 y |
| ProMACE-Cytabom | 8 | 100 | 86 at 15 y | N/A | 88 at 15 y | ||
| Divine et al61 | ACVBP | 52 | 34 | 85 | N/A | 47 at 5 y | 53 at 5 y |
| Soussain et al11 | LMB 81, 84, 86, and 89 | 65 | 26 (17-65) | 89 | N/A | 71 at 3 y | 74 at 3 y |
| Divine et al62 | LMB 81, 84, 86, and 89 | 51 | 33 | 83 | N/A | 61 at 2 y | 66 at 2 y |
| Hoelzer et al55 | BNHL83 | 24 | 33 (15-38) | 63 | 50 at 8 y | N/A | 49 at 8 y |
| BNHL86 | 35 | 36 (18-65) | 74 | 71 at 4 y | 51 at 4 y | ||
| Todeschini et al63 | Modified POG 8617 | 8 | 35 (19-64) | 100 | N/A | 75 at 28 mo | N/A |
| Adde et al64 | CODOX-M/IVAC | 26 | 25 (18-59) | 92.3 | N/A | 84 at 1 y | N/A |
| LaCasce et al65 | CODOX-M/IVAC | 14 | 47 | 86 | 72 at 21 mo | N/A | N/A |
| Mead et al9 | CODOX-M/IVAC | 52 | 35 (15-60) | 75 | N/A | 64.6 at 2 y | 72.8 at 2 y |
| Thomas et al56 | Hyper-CVAD | 26 | 58 (17-79) | 81 | 61 at 3 y* | N/A | 49 at 3 y |
| Cabanillas et al66 | R-Hyper-CVAD | 20 | 52 (27-77) | 89 | 86 at 1 y | N/A | N/A |
| Lee et al67 | CALGB 9251 | 54 | 44 (18-71) | 80 | 50 at 4 y | N/A | 52 at 4 y |
EFS indicates event-free survival; OS, overall survival; ProMACE-MOPP, methotrexate, doxorubicin, cyclophosphamide, etoposide, mechlorethamine, vincristine, procarbazine, and prednisone; ACVBP, doxorubicin, cyclophosphamide, vindesine, bleomycin, and prednisone; LMB, French B-cell non-Hodgkin lymphoma and B-ALL protocols; NHL, German B-cell non-Hodgkin lymphoma protocols; POG, Pediatric Oncology Group; CODOX-M/IVAC, cyclophosphamide, vincristine, doxorubicin, high-dose methotrexate/ifosfamide, etoposide, high-dose cytarabine; hyper-CVAD, hyperfractionated cyclophosphamide, vincristine, doxorubicin, dexamethasone, methotrexate, and cytarabine; R, rituximab; CALGB, Cancer and Leukemia Group B.
Some of the earliest reports of successful treatment regimens for adult BL include the Vanderbilt and Stanford regimens.10,58 After noting poor outcomes with conventional intermediate-grade lymphoma regimens like BACOP (bleomycin, doxorubicin, cyclophosphamide, vincristine, and prednisone) and COMP (cyclophosphamide, vincristine, methotrexate, and prednisone), McMaster et al10 treated 20 patients with 2 intensive inpatient induction courses. With this regimen containing high-dose cyclophosphamide, methotrexate (200 mg/m2), bleomycin, vincristine, and doxorubicin, CRs were achieved in 85% of patients, and 5-year DFS reached 60%. The Stanford group achieved similar results with a regimen containing high-dose cyclophosphamide (1500 mg/m2) and mid-cycle high-dose methotrexate (3000 mg/m2) administered over 6 to 9 cycles (Figure 5).58 With this regimen, 2-year OS reached 66.8%; however, the best responses were noted in patients with limited-stage disease (a single extra-abdominal tumor site or a completely resected intra-abdominal disease), where 2-year OS was 100%, compared with 53.8% in the advanced setting.58
In 1995 and 1996, 2 reports were published that documented the success of adapting the pediatric French LMB and the German BFM regimens to the treatment of adult BL.11,55 In a retrospective review of 65 adults treated according to the pediatric LMB 81, 84, 86, and 89 regimens, 58 patients (89%) achieved a CR with a 3-year OS of 74%, despite the fact that most patients had advanced-stage disease or evidence of leukemic involvement.11 Seven of 12 patients who presented with CNS involvement remained disease free up to 56 months after therapy. These LMB protocols (Figure 5) consist of an initial cytoreductive phase, using cyclophosphamide and prednisone to rapidly diminish the tumor burden and to minimize the risk of tumor lysis, followed by 2 induction cycles, 1 to 2 consolidation cycles, and 1 to 4 maintenance cycles. A prospective study of the LMB protocol in adults confirmed the retrospective findings, with a CR rate of 83% and a 2-year OS of 66%.62
On the basis of their success in pediatric BL with the BFM protocols, the German Multicenter Study Group for the treatment of adult ALL (GMALL) developed 2 protocols, B-NHL 83 and B-NHL 86, for the treatment of adult Burkitt leukemia.55 Similar to the LMB trials, these studies also included a cytoreductive phase to minimize the risk of tumor lysis. Following this pre-phase, 6 cycles of alternating chemotherapy regimens were given, with fractionated cyclophosphamide, methotrexate, and low-dose cytarabine in each of these alternating cycles. The B-NHL 86 regimen (Figure 5) escalated the dose of methotrexate to 1500 mg/m2 and added ifosfamide to the B-NHL 83 regimen. Results were comparable to those noted in the French LMB trials, with 4- to 8-year OS reaching 49% to 51%.55
Magrath et al54 pioneered the use of the CODOX-M/IVAC regimen in children and adults with BL. This regimen incorporates 3 cycles of CODOX-M for patients with low-risk disease (a single extranodal site or completely resected intra-abdominal disease and a normal LDH) and 4 cycles of alternating CODOX-M/IVAC for patients with high-risk disease (Figure 5). CODOX-M/IVAC combines fractionated cyclophosphamide with higher doses of methotrexate (6720 mg/m2) and cytarabine (2000 mg/m2) than administered in the LMB and B-NHL trials, with the exception of LMB 86 in which patients received up to 8000 mg/m2 methotrexate. In the initial publication, 2-year EFS was 85% in children and 100% in adults, with all 20 adult patients achieving a CR.54 In an updated report, CRs were noted in 24 of 26 adult patients treated, with 22 patients alive and disease free, at a median follow-up of 47 months (range, 12-91 months).64 While the results of this study seem remarkable, it is important to recognize that this study involved a relatively young adult patient population, with a median age of 25 years, although 70% of patients had advanced-stage disease by both the St Jude and the Ann Arbor staging systems. A trial using this regimen in Europe reported 2-year EFS and OS of 64.6% and 72.8%, respectively, in 52 patients with a median age of 35 years.9 In 14 patients with a median age of 47 years, the Magrath regimen produced responses in 86% of patients, with 72% alive and disease free after 21 months of follow-up.65 In this older group, myelosuppression was universal, and treatment-related deaths were reported in 5 patients.9,65
Two other regimens have been examined exclusively in adults, namely Hyper-CVAD and a CALGB regimen, CALGB 9251. With the Hyper-CVAD regimen (Figure 5), a modified Murphy regimen used to treat adult Burkitt leukemia at MD Anderson, 81% of patients achieved a CR, and the 3-year OS was 49%.56 Notably, this study contained a much older population of patients (median age, 58 years) than reported in other trials, and patients 60 years or older had an inferior outcome (3-year OS of 17% versus 77%).56 The CALGB regimen contains a cytoreductive phase, followed by 3 cycles each of 2 different regimens administered every 3 weeks (Figure 5).67 In 54 evaluable patients, CRs were noted in 80%, with 4-year DFS of 50%. However, severe neurologic toxicity (transverse myelitis, peripheral neuropathy, aphasia, cortical blindness, and dementia) was observed in 10 of 74 patients enrolled on this trial, attributed to the combination of high-dose methotrexate (1500 mg/m2), triple intrathecal chemotherapy, and whole brain irradiation (24 Gy) used for CNS prophylaxis. The cranial radiation was subsequently eliminated for patients without bone marrow involvement at presentation and the rate of neurologic events decreased. In the CALGB study, only 32% of patients older than 50 years were able to complete 6 to 7 cycles of treatment, compared with 79% of younger patients.67 Mortality (21% versus 9%), disease progression (32% versus 3%), and toxicity (16% versus 9%) were noted to be higher in those patients older than 50 years.67 The higher rate of relapse in elderly patients with BL implies that these poor outcomes may not simply be related to treatment-related toxicity. Thomas et al56 noted an increased incidence of complex cytogenetic abnormalities in older patients, including bcl-2 gene rearrangements, which may contribute to a more aggressive phenotype.
As demonstrated by the trials previously discussed and as is summarized in Table 3, several issues remain unresolved in the treatment of adult BL; in particular, the optimal dose and fractionation schedule of cyclophosphamide, the optimal dosage of methotrexate and cytarabine, and the necessity of ifosfamide. Murphy et al49 piloted the use of fractionated cyclophosphamide (6 doses of 300 mg/m2 every 12 hours) in pediatric patients with BL, postulating that a fractionated schedule would ensure exposure of every dividing tumor cell to the active alkylating metabolites of cyclophosphamide. The optimal fractionation schedule remains unclear, with administration of cyclophosphamide varying from every 12 hours49,56 to every 24 hours.11,54,55,67 In addition, it is also unclear whether the fractionation or simply the dose intensity is important in BL. For example, the Stanford regimen incorporates a single dose of high-dose cyclophosphamide.58 Nevertheless, several studies have incorporated fractionated cyclophosphamide into adult BL regimens on the basis of the efficacy described in the pediatric literature with the Murphy, German BFM, and the French LMB regimens.49,50,53,69 The appropriate dosage of methotrexate and cytarabine also remains unsettled. Although most trials incorporate high-dose methotrexate and cytarabine to improve CNS prophylaxis, the benefit is unclear, and escalated doses increase toxicity, particularly in older patients. Treatment with up to 8000 mg/m2 methotrexate and 3000 mg/m2 cytarabine have been reported11,56 ; however, lower doses (1000-3000 mg/m2 methotrexate and 100-150 mg/m2 cytarabine) may be equally efficaceous.55,56,67 Last, it is unclear if ifosfamide provides any benefit in addition to the cyclophosphamide routinely incorporated into initial therapy, with 2 recent trials failing to demonstrate any improvement in EFS or OS with the addition of ifosfamide to the therapy of advanced-stage pediatric patients with BL.70,71
Comparison of the cyclophosphamide, methotrexate, cytarabine, and ifosfamide doses, and IT prophylaxis in reported treatment regimens for adult BL
Reference . | Protocol . | Duration, no. of cycles . | Cyclophosphamide, mg/m2* . | Methotrexate, mg/m2* . | Cytarabine, mg/m2* . | Ifosfamide, mg/m2* . | IT prophylaxis . |
|---|---|---|---|---|---|---|---|
| Bernstein et al58 | Stanford | 6-9 | 1200 | 3000 | None | None | IT MTX |
| Lopez et al59 | MD Anderson 81-01 | 15 | 1000 × 1 dose | 1000 | 20 q 8 h × 15 doses | 1000 × 5 doses | IT MTX, ARA-C, and HC |
| MD Anderson 84-30 | 9 | 1000 × 1 dose | 1000 | 500 × 1 dose and 20 q 8 h × 15 doses | None | IT MTX, ARA-C and HC | |
| McMaster et al10 | Vanderbilt | 2 | 1500 × 2 doses | 200 | None | None | Given at investigator's discretion |
| Longo et al60 | ProMACE-MOPP | 6-9 | 500-650 × 1-2 doses | 500-3000 | None | None | CNS XRT if BM positive |
| ProMACE-Cytabom | 6 | 650 × 1 dose | 120 | 300 | None | CNS XRT if BM positive | |
| Divine et al61 | ACVBP | 8 | 1200 | 3000 as maintenance for patients with a CR only | For patients in CR only | For patients in CR only | IT MTX and HC |
| Soussain et al11 | LMB 81, 84, 86, and 89 | 4-7† | Cytoreduction: 300 × 1 dose | Cytoreduction: None | Cytoreduction: None | Cytoreduction: None | IT MTX, ARA-C, and HC (CNS XRT only if + CNS disease) |
| Induction: 500-1000 × 3 doses | Induction: 3000-8000 | Induction: None | Induction: None | ||||
| Consolidation: None | Consolidation: 3000 | Consolidation: 100-3000 × 4-5 doses | Consolidation: None | ||||
| Hoelzer et al55 | B-NHL 83 | 6 | Cytoreduction: 200 × 5 doses | Cytoreduction: none | Cytoreduction: none | Cytoreduction: none | |
| Treatment: 200 × 5 doses | Treatment: 500 | Treatment: 300 | CNS XRT, IT MTX (spinal XRT if + CNS disease) | ||||
| B-NHL 86 | 6 | Cytoreduction: 200 × 5 doses | Cytoreduction: none | Cytoreduction: none | Cytoreduction: none | ||
| Treatment: 200 × 5 doses | Treatment: 1500 | Treatment: 150 q 12 h × 8 doses | Treatment: 800 × 5 doses | CNS XRT, IT MTX, ARA-C, and DEX (spinal XRT if + CNS disease) | |||
| Todeschini et al63 | Modified POG 8617 | 6 | 300 q 12 h × 6 doses | 1000 | 3000 q 12 h × 4 doses | None | IT MTX and ARA-C |
| Magrath et al54,64 | CODOX-M/IVAC | Low risk: 3 CODOX-M | 800 × 1 dose and 200 × 4 doses | 6720 | None | None | IT MTX & ARA-C (CNS XRT only if + CNS disease) |
| High risk: 4 CODOX-M/IVAC | 800 × 1 dose and 200 × 4 doses | 6720 | 2000 q 12 h × 4 doses | 1500 × 5 doses | IT MTX & ARA-C (CNS XRT only if + CNS disease) | ||
| Thomas et al56 | Hyper-CVAD | 8 | 300 q 12 h × 6 doses for 4 cycles | 1000 for 4 cycles | 3000 q 12 h × 4 doses for 4 cycles | None | IT MTX and ARA-C (CNS XRT only if + CNS disease) |
| Lee et al67 | CALGB 9251 | 6 | Cytoreduction: 200 × 5 doses | 1500 | 150 × 2 doses | 800 × 5 doses | IT MTX, ARA-C, HC, and CNS XRT |
| Treatment: 200 × 5 doses |
Reference . | Protocol . | Duration, no. of cycles . | Cyclophosphamide, mg/m2* . | Methotrexate, mg/m2* . | Cytarabine, mg/m2* . | Ifosfamide, mg/m2* . | IT prophylaxis . |
|---|---|---|---|---|---|---|---|
| Bernstein et al58 | Stanford | 6-9 | 1200 | 3000 | None | None | IT MTX |
| Lopez et al59 | MD Anderson 81-01 | 15 | 1000 × 1 dose | 1000 | 20 q 8 h × 15 doses | 1000 × 5 doses | IT MTX, ARA-C, and HC |
| MD Anderson 84-30 | 9 | 1000 × 1 dose | 1000 | 500 × 1 dose and 20 q 8 h × 15 doses | None | IT MTX, ARA-C and HC | |
| McMaster et al10 | Vanderbilt | 2 | 1500 × 2 doses | 200 | None | None | Given at investigator's discretion |
| Longo et al60 | ProMACE-MOPP | 6-9 | 500-650 × 1-2 doses | 500-3000 | None | None | CNS XRT if BM positive |
| ProMACE-Cytabom | 6 | 650 × 1 dose | 120 | 300 | None | CNS XRT if BM positive | |
| Divine et al61 | ACVBP | 8 | 1200 | 3000 as maintenance for patients with a CR only | For patients in CR only | For patients in CR only | IT MTX and HC |
| Soussain et al11 | LMB 81, 84, 86, and 89 | 4-7† | Cytoreduction: 300 × 1 dose | Cytoreduction: None | Cytoreduction: None | Cytoreduction: None | IT MTX, ARA-C, and HC (CNS XRT only if + CNS disease) |
| Induction: 500-1000 × 3 doses | Induction: 3000-8000 | Induction: None | Induction: None | ||||
| Consolidation: None | Consolidation: 3000 | Consolidation: 100-3000 × 4-5 doses | Consolidation: None | ||||
| Hoelzer et al55 | B-NHL 83 | 6 | Cytoreduction: 200 × 5 doses | Cytoreduction: none | Cytoreduction: none | Cytoreduction: none | |
| Treatment: 200 × 5 doses | Treatment: 500 | Treatment: 300 | CNS XRT, IT MTX (spinal XRT if + CNS disease) | ||||
| B-NHL 86 | 6 | Cytoreduction: 200 × 5 doses | Cytoreduction: none | Cytoreduction: none | Cytoreduction: none | ||
| Treatment: 200 × 5 doses | Treatment: 1500 | Treatment: 150 q 12 h × 8 doses | Treatment: 800 × 5 doses | CNS XRT, IT MTX, ARA-C, and DEX (spinal XRT if + CNS disease) | |||
| Todeschini et al63 | Modified POG 8617 | 6 | 300 q 12 h × 6 doses | 1000 | 3000 q 12 h × 4 doses | None | IT MTX and ARA-C |
| Magrath et al54,64 | CODOX-M/IVAC | Low risk: 3 CODOX-M | 800 × 1 dose and 200 × 4 doses | 6720 | None | None | IT MTX & ARA-C (CNS XRT only if + CNS disease) |
| High risk: 4 CODOX-M/IVAC | 800 × 1 dose and 200 × 4 doses | 6720 | 2000 q 12 h × 4 doses | 1500 × 5 doses | IT MTX & ARA-C (CNS XRT only if + CNS disease) | ||
| Thomas et al56 | Hyper-CVAD | 8 | 300 q 12 h × 6 doses for 4 cycles | 1000 for 4 cycles | 3000 q 12 h × 4 doses for 4 cycles | None | IT MTX and ARA-C (CNS XRT only if + CNS disease) |
| Lee et al67 | CALGB 9251 | 6 | Cytoreduction: 200 × 5 doses | 1500 | 150 × 2 doses | 800 × 5 doses | IT MTX, ARA-C, HC, and CNS XRT |
| Treatment: 200 × 5 doses |
Note that the reported regimens also contain several chemotherapeutic agents, including doxorubicin, vincristine, dexamethasone, or prednisone, and others not reported in this table. CNS XRT indicates whole-brain irradiation; BM, bone marrow; IT, intrathecal; MTX, methotrexate, ARA-C, cytarabine; HC, hydrocortisone; DEX, dexamethasone; PRED, prednisolone.
All chemotherapy doses are total doses per cycle unless otherwise noted.
Duration was in months.
Several investigators have incorporated upfront autologous stem cell transplantation into their treatment regimens for BL. To date none of these studies appear to improve upon the results observed with brief-duration, intensive chemotherapy alone for BL. Three-year OS rates of 60% to 72% have been reported following autologous stem cell transplantation in first CR,72,73 similar to that attained with chemotherapy alone. Treatment-related mortality may exceed that of chemotherapy alone in those patients receiving up-front transplants, as demonstrated by data from the French LMB trials in which 54% (7 of 13) of patients who underwent transplantation in first CR (6 allogeneic and 7 autologous) survived, compared with 89% (40 of 45) of patients receiving chemotherapy only.11 Therefore, on the basis of these small studies, there is no role for transplantation in first CR in BL.
Central nervous system prophylaxis in BL
As CNS involvement is common in BL, CNS prophylaxis is required for the treatment of all adults with BL. Most BL regimens take a combination approach to CNS prophylaxis, relying on the efficacy of high-dose methotrexate, high-dose cytarabine, and intrathecal chemotherapy in the prevention of CNS relapse. Some earlier studies have incorporated whole brain and occasionally spinal radiation into the prophylaxis regimen (Table 3); however, there are no data to support that these modalities improve outcomes over combination therapy with intravenous and intrathecal chemotherapy alone. In addition, as demonstrated by the CALGB trial,67 the risk of long-term, severe neurotoxicity is higher with the addition of radiation to intrathecal chemotherapy and high-dose methotrexate. Therefore, currently there is no role for prophylactic cranial or spinal irradiation in the treatment of BL when CNS prophylaxis is provided by intrathecal chemotherapy coupled with high-dose systemic methotrexate, cytarabine, or both.
Treatment of limited-stage BL
Several studies have noted very favorable results in early-stage (Ann Arbor stages I-III or St Jude stages I-II) BL, with CR rates of 100% and 2- to 5-year freedom from progression (FFP) rates of 95% to 100%, compared with CR rates of 57% and 2- to 5-year FFP rates of 29% to 60% in the advanced setting.58,59 On the basis of these very encouraging results, 3 cycles of CODOX-M or the Stanford protocol may be suitable for those patients who present with limited disease. With the Magrath regimen, low-risk patients received 3 cycles of CODOX-M without alternating IVAC, whereas in the Stanford series, patients with limited stage disease received 6 cycles of therapy rather than 9.54,58 Two-year EFS of 83% to 100% has been observed with these regimens in low-risk patients.9,54,58 Therefore, very brief-duration regimens may be feasible in early-stage BL.
Therapy-related toxicity in BL
In most trials, the most commonly encountered toxicities have consisted of myelosuppression and infections. With the Vanderbilt and Stanford regimens, leukopenia was reported in 100% and 23.4% of cycles, respectively, with 3 treatment-related deaths as a result of either tumor lysis syndrome or sepsis.10,58 With the LMB, B-NHL 83 and 86, CODOX-M/IVAC, and Hyper-CVAD regimens, neutrophil counts below 500 cells/μL were reported in 81% to 100% of cycles, platelet transfusions were required in 35% to 71%, and severe infections were reported in 19% to 55% of patients.11,54-56 Mucositis, cerebellar toxicity, and thrombocytopenia-related hemorrhage have also been reported. To minimize some of these toxicities, many regimens incorporate fungal, bacterial, and viral prophylaxis and administer colony-stimulating factors, although the value of these agents is unknown. All patients treated with Hyper-CVAD received granulocyte colony-stimulating factor (GCSF) at a dose of 10 μg/kg starting 24 hours after chemotherapy.56 With GCSF, the average time to neutrophil recovery was 17 days and was similar in both the younger than 60 and the 60 or older age groups.56 With the Magrath regimen, low-risk and high-risk patients were randomly assigned to receive granulocyte-macrophage colony-stimulating factor (GM-CSF).54 There was no difference in the control and GM-CSF arms with respect to incidence of documented infection, duration of neutropenia, and incidence of fever of unknown origin; however, patients treated with GM-CSF did experience delayed platelet recovery.54 In regard to prophylactic antibiotics, antifungals, and antivirals, limited data are available addressing their use in this setting, with such treatment incorporated into the Hyper-CVAD regimen56 but not reported as part of the CODOX-M/IVAC, B-NHL, LMB, or CALGB regimens.11,54,55,68 It is the authors' approach to administer GCSF in adult patients with BL and to apply aggressive prophylactic measures similar to that recommended for the management of acute leukemia.74
Prognostic features, salvage therapy, and stem cell transplantation (SCT) in BL
While debate is ongoing over the most relevant prognostic factors in BL, several studies have identified advanced age, advanced stage, poor performance status, CNS or bone marrow involvement, anemia, the presence of circulating blasts, and an elevated LDH as indicative of a poor outcome in adult BL.9,56,59,61 Not all series report bone marrow or CNS involvement as poor prognostic features,55,56 suggesting that the incorporation of fractionated cyclophosphamide, high-dose methotrexate, cytarabine, or intensive intrathecal chemotherapy into the current treatment regimens may improve outcomes in this historically poor-performing group. The validity of these prognostic factors remains questionable, however, because many of these factors were identified in single institution phase 2 studies with selected patient populations.
Most patients attain CR within 4 to 6 weeks of initiating therapy for BL.56,58 With the Hyper-CVAD regimen, the median time to CR was 22 days and 70% of patients achieved a CR within the first 4 weeks of therapy.56 For those patients who relapse, this generally occurs within the first year, although relapses have been reported 17 to 55 months after the completion of therapy.9,11,56,61,62 Failure to achieve a CR is a particularly poor prognostic sign. All patients who achieve a PR have been found to relapse and die of progressive disease without additional therapy.54,58,61 Therefore, patients should be followed very closely for a response, with disease assessed after 6 to 8 weeks of therapy, and alternative therapy rapidly initiated for those patients failing to achieve a CR. Patients with bulky abdominal masses who fail to have complete radiographic resolution of this mass may require repeat biopsy or imaging with positron emission tomography (PET) or gallium scan to ascertain CR.
For those patients with a PR or relapsed disease, the optimal salvage strategy is unknown. Combination chemotherapy with non–cross-reactive agents, including cytarabine, ifosfamide, or cisplatin, can be provided, particularly if these agents were not used front-line. However, even with non–cross-resistant chemotherapy, few to no patients with BL respond at the time of relapse. Autologous or allogeneic stem cell transplantation may represent an alternative strategy in the salvage setting; however, published series addressing high-dose therapy in BL are confounded by both selection bias and absence of detailed pathologic review. In a retrospective review from the European Group for Blood and Marrow Transplantation (EBMT), 10 adult patients with BL or BLL in first partial remission, 15 patients in second or greater remission, and 14 patients with primary refractory disease received an autologous stem transplant.73 Three-year OS was 37% for patients with chemosensitive relapse and 7% for patients with chemorefractory disease. In adult patients treated according to the LMB protocols, 3 patients who received an autologous transplant for refractory disease died.11 In this same trial, 1 of 2 patients treated with an allogeneic transplant and 1 patient treated with an autologous transplant at the time of second CR were alive 24 and 59 months following the transplant.11 Even less data are available regarding the efficacy of related or unrelated allogeneic transplantation in patients with BL.11,75,76 From 1982 to 1998, 71 patients (aged 4-48 years) with BL were reported to have received allogeneic transplant (63 matched related, 3 matched unrelated, and 4 unmatched related) at the time of either first CR or relapse.77 Seventy-three percent of patients had chemosensitive disease, whereas 20% were reported to have chemoresistant disease. As has been seen with autologous transplantation, disease status at transplantation (first CR and chemosensitivity) have a significant effect on OS.77 Interestingly, the presence of acute graft-versus-host disease had no affect on survival.77 In matched patients treated with an autologous transplant, the relapse rate was equivalent between the allogeneic and autologous arms and OS was superior in the autologous arm. These data call into question the existence of a graft-versus-lymphoma effect in BL. In conclusion, with few effective salvage strategies for BL and limited data regarding the role of stem cell transplantation at the time of relapse, the authors recommend that patients with BL participate in a clinical trial at the time of relapse, with consideration given to a stem cell transplantation for those patients who demonstrate chemosensitivity.
Treatment of immunodeficiency-associated BL
Patients positive for HIV have been included in several of the previously described chemotherapy trials in BL.10,57,59 Twelve of 13 patients positive for HIV receiving Hyper-CVAD (9 of whom received therapy in conjunction with highly active antiretroviral therapy [HAART]) achieved a CR, with 8 patients remaining in CR a median of 31 months after diagnosis.57 The median survival was 12 months, and this correlated with the addition of HAART to the treatment regimen. All 4 patients not receiving HAART in conjunction with chemotherapy died. All 13 patients receiving Hyper-CVAD required multiple red cell and platelet transfusions, and 21% required dose modifications because of prolonged myelosuppression.57 Thirty-five percent of cycles were complicated by fever or infections, including fungal pneumonia, cytomegalovirus (CMV) retinitis, and Xanthomonas maltophilia sepsis.57 Therefore, patients positive for HIV with BL can be successfully treated with intensive chemotherapy, but close observation with transfusion support and antibiotic therapy is necessary. The addition of HAART to these regimens may improve outcomes and minimize the risk of opportunistic infections, but further evaluation is needed.
New modalities for the treatment of BL
Despite the improvement in CR, DFS, and OS rates with intensive chemotherapy in BL, novel treatment regimens are needed, particularly for patients with poor prognostic features at diagnosis, patients who fail to attain a CR, and patients who relapse. With the frequent expression of CD20 in BL, the monoclonal anti-CD20 antibody rituximab may improve outcomes in BL in both the front-line and relapsed settings. Rituximab has recently been incorporated into the Hyper-CVAD regimen (R-Hyper-CVAD), with dosing on days 1 and 11 of cycles 1 and 3 and on days 1 and 8 of cycles 2 and 4.66 To date, 20 patients (80% with Ann Arbor stage III-IV disease) have received R-Hyper-CVAD, with CRs reaching 89% and a 1-year DFS of 86%. The CALGB has also incorporated rituximab into its latest BL regimen (CALGB 10002), with rituximab administration occurring during each cycle except the cytoreductive phase. This study is currently accruing patients and is expected to take 3 years to complete. Other monoclonal antibodies directed at other common B-cell antigens, namely CD22 and HLA-DR may also have a future role in the treatment of BL.
Other novel therapies that may have potential benefit, but have not yet been evaluated in BL, include DNA methyltransferase inhibitors, histone deacetylase inhibitors, antisense oligonucleotides targeting c-Myc, proteasome inhibitors, cyclin-dependent kinase inhibitors, selective serotonin re-uptake inhibitors (SSRIs), and blockade of EBV-related viral proteins. Hypermethylation of death-associated protein (DAP)–kinase, p16INK4a, and p15INK4B,46,48 and the interaction of the Myc/Max (Myc-associated factor X) heterodimers with a histone acetyltransferase78 in BL suggests that epigenetic modifications are important in BL and could be therapeutically targeted by DNA methytransferase inhibitors (ie, decitabine or 5-azacytidine) or histone deacetylase inhibitors (ie, depsipeptide, MS-275, or suberoylanilide hydroxamic acid). Pilot studies with antisense oligonucleotides directed at several different sites of human c-Myc mRNA have been reported to decrease proliferation of HL-60 and Raji cells in vitro.79 In a murine model of BL, treatment with a DNA phosphorothioate oligonucleotide complementary to c-myc codons 1 to 5 or 384 to 388 delayed tumor onset by 3 to 6 days and decreased total tumor mass by 40% to 65%, compared with controls.80 Proteasome inhibition may also effectively induce apoptosis in BL cell lines,81 despite previously demonstrated defects in proteasome-mediated degradation of c-Myc in BL.38,39 In severe combined immunodeficiency mice bearing BL tumors, treatment with a proteasome inhibitor (Z-LLF-CHO) led to tumor regression.81 Serafeim et al82,83 have recently published intriguing in vitro data, suggesting that SSRIs (fluoxetine, paroxetine, and citalopram) rapidly trigger apoptosis of BL cells, with little effect on normal germinal center B cells. The mechanism of SSRI-mediated apoptosis remains unclear; however, preliminary studies suggest that this may occur independently of blockade of the serotonin transporter. Finally, although EBV-related viral proteins are detected in only about 20% to 50% of sporadic and immunodeficiency-associated BL,8,25,26,84-86 inhibition of viral proteins (EBNA-1 and EBNA-2, in particular) can inhibit cell growth and lead to apoptosis of EBV-immortalized cells in vitro.87,88 Hopefully, in the future, many of these therapeutic strategies targeting known molecular and genetic abnormalities of BL will prove to be effective for adult patients with relapsed or refractory BL.
In conclusion, a remarkable shift in the therapeutic paradigm of BL has occurred. Once thought to be incurable in adults because of its high proliferative rates, BL has proven to be quite chemosensitive even in patients with CNS or bone marrow involvement at presentation. Important strides continue to be made within the field of BL with the incorporation of several active agents from fractionated cyclophosphamide to high-dose methotrexate into a variety of promising treatment regimens. Although the optimal therapeutic strategy for BL is unknown, continued progress in the development of targeted therapies will potentially improve outcomes in this disease.
Prepublished online as Blood First Edition Paper, July 20, 2004; DOI 10.1182/blood-2004-02-0405.
Supported by the National Cancer Institute (P01 CA95426-01A1), The Sidney Kimmel Cancer Research Foundation, The Leukemia and Lymphoma Society of America, and The D. Warren Brown Foundation. J.C.B. is a Clinical Scholar of the Leukemia and Lymphoma Society of America.
![Figure 1. Typical morphology of bone marrow or lymph node involvement in BL. (A) Typical morphology of bone marrow with involvement by BL. Characteristic immunophenotype illustrated by immunohistochemistry: CD20+, CD10+, Ki67+ (100%), TdT– (terminal deoxynucleotidyl transferase), and CD34–. Classic translocation involving c-myc and immunoglobulin heavy chain genes is illustrated by fluorescence in situ hybridization (FISH) analysis with probes for 14q32 (immunoglobulin heavy chain [IgH]), green; 8q24 (MYC), red; and chromosome 8 centromere probe, aqua. Fusion product t(8;14)(q24:q32) in yellow (indicated by arrows). (B) Typical morphology of lymph node with involvement by BL. Characteristic immunophenotype illustrated by immunohistochemistry: CD20+, CD10+, Ki67+ (100%), TdT–, and CD34–. Classic translocation involving c-myc and immunoglobulin heavy chain genes is illustrated by FISH analysis with probes for 14q32 (IgH), green; 8q24 (MYC), red; and chromosome 8 centromere probe, aqua. Fusion product t(8;14)(q24;q32) in yellow (indicated by arrows). The large images of bone marrow and lymph node involvement in panels A and B were obtained using an Olympus BX50 microscope (Olympus, Tokyo, Japan) equipped with an Olympus UPlanF1 40 ×/0.75 objective lens (H&E images of bone marrow and lymph node), or an Olympus UPlanF1 20 ×/0.50 objective lens (CD20, CD10, Ki67, TdT, and CD34 immunohistochemistry stains). Photography was performed with an MTI 3CCD digital camera (DAGE-MTI, Michigan City, IN), PAXit 2.0 acquisition software (MIS, Franklin Park, IL), and Adobe Photoshop 7.0 imaging software (Adobe, San Jose, CA). The immunohistochemical stains were obtained using DAKO autostainer universal staining system (DAKOCytomation, Carpinteria, CA) and the following antibodies: CD10 clone 56C6 (Novocastra, Newcastle upon Tyne, United Kingdom), CD20 clone L26 (DAKOCytomation, Glostrup, Denmark), CD34 clone QBEND10 (Immunotech, Marseilles, France), Ki67 clone MIB-1 (DAKOCytomation), and TdT clone A3524 (DAKOCytomation). The FISH insert images were acquired using the Vysis IgH/MYC/CEP-8 Dual Fusion DNA probe (Vysis/Abbott, Downers Grove, IL), a Zeiss Axioskop microscope equipped with a Zeiss PlanApo 100 × oil immersion objective lens and dual band pass filter (Carl Zeiss, Thornwood, NY), and Applied Spectral Imaging (Vista, CA) digital camera and software version 3.0.](https://ash.silverchair-cdn.com/ash/content_public/journal/blood/104/10/10.1182_blood-2004-02-0405/6/m_zh80220469430001.jpeg?Expires=1769865418&Signature=ghH44Z-~GgJF4Kg~ax2SQDtqVz1LG-GsYCDAAJqOwS7PwfSoYFVnvGC79Innf9GyTkDKocogz0ndoT5cI5yaG9Gt91HG0drQCrbxJfD0oe9V4fRITW3nZeaNmSV8xcQNT4o4tLIYrokB24VfUHgF7tRbmFccnOR0xzJSYHCw-y0CHdF85doVH4euKBNZA~ImkB84FHRZlOqUHAU9U7EyewHI81A9w1fXz-jR0ZsaSufIjktlAzysw1X6JCcBYFin1PiTKKUPwBrkDPClbgO9kjGIhA~pgl~ZrKQEI3~c2jS6nfd9jv3EykUQTlrqAiUqWHFEcCIo28p-p7bNVaOIlg__&Key-Pair-Id=APKAIE5G5CRDK6RD3PGA)

This feature is available to Subscribers Only
Sign In or Create an Account Close Modal